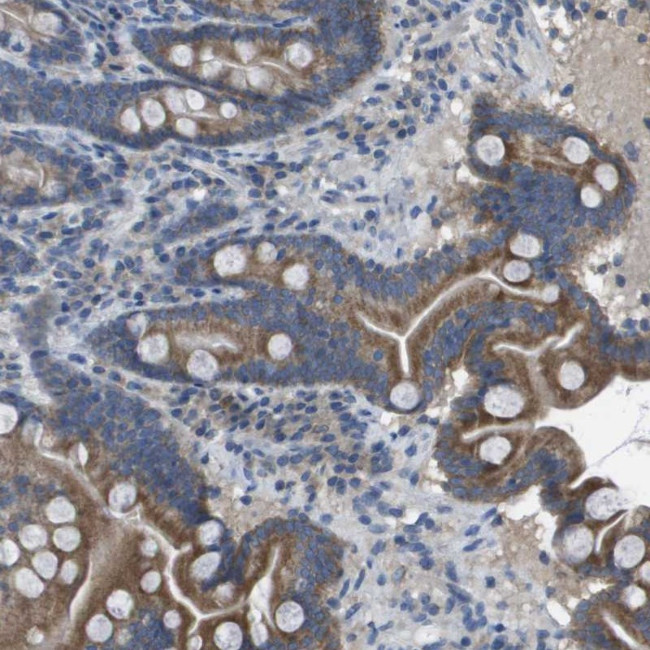
CLCA4 Antibody in Immunohistochemistry (Paraffin) (IHC (P))

Search
Invitrogen
CLCA4 Polyclonal Antibody
{{$productOrderCtrl.translations['antibody.pdp.commerceCard.promotion.promotions']}}
{{$productOrderCtrl.translations['antibody.pdp.commerceCard.promotion.viewpromo']}}
{{$productOrderCtrl.translations['antibody.pdp.commerceCard.promotion.promocode']}}: {{promo.promoCode}} {{promo.promoTitle}} {{promo.promoDescription}}. {{$productOrderCtrl.translations['antibody.pdp.commerceCard.promotion.learnmore']}}
产品信息
PA5-53538
种属反应
宿主/亚型
分类
类型
抗原
偶联物
形式
浓度
规格
纯化类型
保存液
内含物
保存条件
运输条件
RRID
产品详细信息
Immunogen sequence: WVGMVHFDST ATIVNKLIQI KSSDERNTLM AGLPTYPLGG TSICSGIKYA FQVIGELHSQ LDGSEVLLLT DGEDNTASSC IDEV
Highest antigen sequence identity to the following orthologs: Mouse - 67%, Rat - 58%.
靶标信息
The protein encoded by this gene belongs to the calcium sensitive chloride conductance protein family. To date, all members of this gene family map to the same site on chromosome 1p31-p22 and share high degrees of homology in size, sequence and predicted structure, but differ significantly in their tissue distributions. Alternative splicing results in multiple transcript variants, only one of which is thought to be protein coding.
仅用于科研。不用于诊断过程。未经明确授权不得转售。
篇参考文献 (0)
生物信息学
蛋白别名: bovine epithelial chloride channel homolog; CaCC-2; Calcium-activated chloride channel family member 4; Calcium-activated chloride channel protein 2; Calcium-activated chloride channel regulator 4; Chloride channel accessory 4; chloride channel regulator 4; chloride channel, calcium activated, family member 4; hCaCC-2; hCLCA4; unnamed protein product
基因别名: CaCC; CaCC2; CLCA4; UNQ562/PRO1124
UniProt ID: (Human) Q14CN2
Entrez Gene ID: (Human) 22802